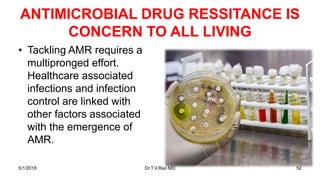
ANTIMICROBIAL DRUG RESSITANCE IS
CONCERN TO ALL LIVING
• Tackling AMR requires a
multipronged effort.
Healthcare associated
infections and infection
control are linked with
other factors associated
with the emergence of
AMR.
5/1/2018 Dr.T.V.Rao MD 52

Embed presentation
Downloaded 91 times








































































The document discusses the critical need for infection control education and national accreditation in healthcare settings, particularly in developing countries where healthcare-associated infections (HCAIs) pose a significant risk. It highlights the extended hospital stays and increased mortality associated with HCAIs, emphasizing the role of antimicrobial resistance as a global health concern. Effective infection control practices, education, and surveillance systems are essential for improving patient safety and managing the emergence of drug-resistant infections.